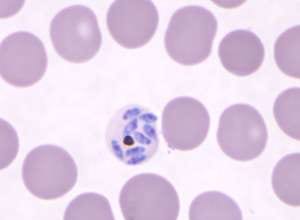

Trending Now
TIN KHOA HỌC CHUYÊN NGÀNH
Robot nano sinh học sẽ giúp chúng ta kết thúc cơn...
Chúng được lắp ráp từ DNA tổng hợp và protein, nên có thể giết chết vi khuẩn kháng thuốc.
Đối mặt với kháng kháng sinh
Kháng...
TIN TỨC, SỰ KIỆN KHOA HỌC CHUNG
Ca bệnh hiếm gặp: bệnh ấu trùng di chuyển ở người...
Mới đây, các nhà khoa học chuyên ngành Ký sinh trùng tại Việt Nam đã phát hiện và công bố một trường hợp bệnh...
Sau điều trị bao lâu thì khỏi bệnh do giun đũa...
Đây là câu hỏi được rất nhiều người đặt ra cho các y bác sĩ khi mắc bệnh do giun đũa chó mèo. Lý...
HOẠT ĐỘNG CỦA HỘI
TÀI NGUYÊN
Luận án tiến sĩ: THỰC TRẠNG NHIỄM VÀ HIỆU QUẢ ĐIỀU...
LUẬN ÁN TIẾN SĨ
Tên luận án: THỰC TRẠNG NHIỄM VÀ HIỆU QUẢ ĐIỀU TRỊ GIUN TRUYỀN QUA ĐẤT BẰNG ALBENDAZOL, MEBENDAZOL Ở TRẺ TỪ...
Số 1 (115)/2020 – TẠP CHÍ PHÒNG CHỐNG BỆNH SỐT RÉT...
Thực trạng hệ thống giám sát và các yếu tố ảnh hưởng trong chiến lược phòng chống và loại trừ sốt rét tại hai...